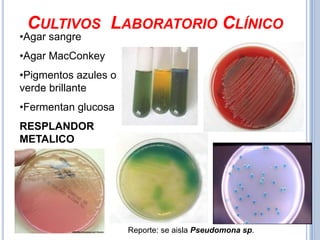
CULTIVOS LABORATORIO CLÍNICO
•Agar sangre
•Agar MacConkey
•Pigmentos azules o
verde brillante
•Fermentan glucosa
RESPLANDOR
METALICO




                      Reporte: se aisla Pseudomona sp.

Este documento describe el género Acinetobacter, que incluye bacterias gramnegativas que son comensales de humanos y animales. Son patógenos oportunistas que pueden causar infecciones, especialmente en pacientes hospitalizados o inmunocomprometidos. Acinetobacter baumannii es la especie más frecuentemente involucrada en infecciones nosocomiales.